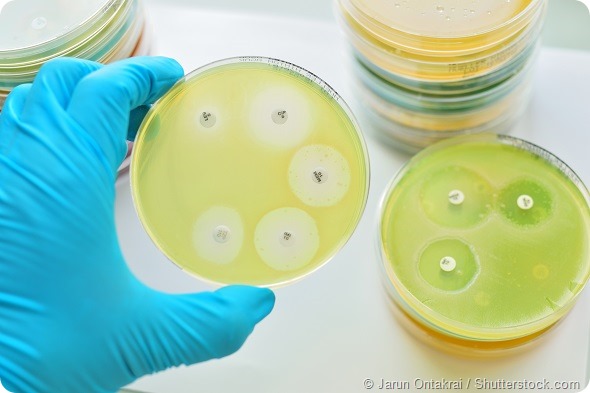
Antimicrobial susceptibility testing in petri dish

Penicillin was one of the first antibiotics developed and has saved millions of lives. First used in the early 1940s, penicillin is still one of the most widely used and least toxic family of antibiotics.
Many penicillins are relatively narrow spectrum antibiotics that kill common pathologic bacteria, and do not disrupt helpful bacteria as much as broad spectrum antibiotics.
Penicillins act by binding to amino acids and disrupting bacterial cell walls. They can also bind to human serum proteins and cause allergic and other immunologically-mediated adverse reactions.
How many people are allergic to penicillin?
Currently about 6.8% of the United States population that uses healthcare services carries a history of a penicillin “allergy” and about 9.9% of hospitalized individuals carry a history of penicillin “allergy.”
What are the risk factors for penicillin “allergy?”
These include overuse and misuse of penicillins, being the female gender, underlying comorbidities (such as migraine misdiagnosed as sinusitis or chronic urticaria), older age, and exposure to aged injectable penicillins.
If a person has a history of penicillin “allergy,” why is confirmation important?
The standard care for patients with a penicillin “allergy” over the years has been to just avoid penicillins, but we now know there are significant risks to just avoidance.
Studies show that patients who report being penicillin-allergic suffer more morbidity, incur higher healthcare costs, and are often prescribed more dangerous, broad spectrum antibiotics that can lead to drug-resistant bacteria (“super bugs”).
So getting penicillin allergy tested is critical, since a self-reported, non-confirmed penicillin “allergy” may deny the patient a safer, effective, and better-tolerated treatment.

Are healthcare providers changing the way they evaluate penicillin allergy?
Based largely on clinical studies we have published, the Centers for Disease Control and Prevention (CDC), the Infectious Diseases Society of America (IDSA), and the Society for Healthcare Epidemiology of America (SHEA) currently recommend penicillin allergy testing for individuals with a history of penicillin “allergy” as part of a comprehensive antibiotic stewardship program to help promote safe and effective antibiotic use.
Penicillin allergy testing has also been a Choosing Wisely recommendation of the American Academy of Allergy, Asthma, and Immunology and the American Board of Internal Medicine since 2014.
What is involved in penicillin allergy testing?
Simple testing can determine a true penicillin allergy. Penicillin allergy testing can be performed by Allergists/Immunologists and other individuals trained in skin testing and managing acute allergic reactions.
The current reference standard test to determine acute penicillin tolerance is an oral challenge with a therapeutic penicillin dose, typically the most widely used penicillin, amoxicillin, and one hour of observation. Penicillin skin testing is done to prevent serious oral amoxicillin challenge reactions.
The rate of positive penicillin allergy evaluations has been falling over the past 50 years. Even if truly present at one point in time, clinically significant penicillin allergy may wane over time in most (but not all) individuals, though the kinetics of this process are not well established.
What are the specific risks of a false penicillin allergy?
Little was known about the risks associated with an unconfirmed penicillin “allergy” until our publications on this issue over the past two decades.
We have shown that less than four percent (4%) of individuals with a penicillin “allergy” currently are penicillin allergy test positive.
Our research has also shown that an unconfirmed penicillin “allergy” in hospitalized patients is associated with increased hospital utilization and increased prevalence of serious drug resistant infections such as Clostridium difficile, methicillin resistant Staphylococcus aureas (MRSA), and vancomycin resistant enterococcus (VRE).
In addition, we have shown that testing large numbers of people for penicillin allergy, in advance of need, is safe and results in more appropriate antibiotic use, less healthcare utilization, and is very cost effective.
Penicillin allergy testing has been shown to save over 20 times as much as it costs in reduced healthcare utilization over a 3+ year follow-up period, and the savings continue year after year.
Who can be safely tested?
Almost everyone with a history of penicillin “allergy” can be safely tested for penicillin allergy.
This includes individuals who had anaphylaxis, hives, other benign rashes, gastrointestinal symptoms, headaches, other benign symptoms, or unknown reactions associated with previous penicillin use.
If there is a history of any of the following extremely rare serious adverse reactions associated with previous penicillin use, then no testing or rechallenge should be attempted.
This includes any penicillin-associated serious cutaneous adverse reactions (SCARs) such as drug reaction with eosinophilia and systemic symptoms (DRESS), toxic epidermal necrolysis (TEN), or Stevens Johnson Syndrome (SJS), and serious hepatitis, hemolytic anemia, interstitial nephritis, or documented serum sickness-like reactions (SSLRs).
Certain individuals with a very low risk of a repeat adverse reaction can undergo a direct oral amoxicillin challenge without penicillin skin testing prior to the challenge.
These include individuals with a history of delayed onset macular-papular rashes, upset stomach, headaches, other benign symptoms, or unknown symptoms.
Direct oral challenges have been studied in both adults and children with mainly delayed onset amoxicillin-associated rashes. Most of these rashes occur in the setting of a viral infection, mistreated with an antibiotic.
All individuals with higher risk histories, including any with a history of anaphylaxis, shortness of breath, hives within six hours of an index penicillin exposure, a recent adverse reaction, or if there is any worry from the patient or the treating physician about a direct oral challenge, should have penicillin skin testing performed first.
What are the technical specifications for the test?
The major determinant, penicilloyl-poly-lysine, is the essential reagent needed for penicillin skin testing. Puncture followed by intradermal testing is recommended.
Only use 0.01 to 0.02 ml of penicilloyl-poly-lysine for intradermal skin testing. It is critical to use at least 5 mm of wheal, with flare greater than wheal, as the criteria for a positive penicillin puncture or intradermal test result.
If the penicillin skin testing is negative, then proceed with an oral challenge using a therapeutic dose of amoxicillin, typically 250 mg, and at least one hour of observation.
An oral amoxicillin challenge with a therapeutic dose, 250 mg to 1500mg, is very safe, with no fatalities identified in about 100,000,000 oral amoxicillin courses over 35 years.
Penicillin use after negative penicillin allergy testing will still result in some adverse event after about 3% of all future penicillin class antibiotic courses, because all antibiotic use is associated with side effects.
Resensitization or new IgE-mediated sensitization after a negative penicillin allergy test however is very rare. In penicillin allergy test negative individuals given therapeutic penicillins, about 3% will note a new reaction per course, but only about 1 in 33 of those will be repeat penicillin allergy test positive.
Currently available commercially available blood tests for penicillin allergy are not useful in evaluating penicillin allergy because they do not correlate to oral challenge reactions.
Oral desensitization can be used in penicillin allergic individuals who require penicillin for life-threatening infections.
To summarize:
All individuals with a history of penicillin “allergy” should consider being evaluated for penicillin allergy testing – specifically all hospitalized individuals, anyone anticipating a hospitalization, and all individuals who use on average one or more courses of antibiotics per year.
Key reasons to get tested include:
- Get the safest, most effective and well-tolerated treatment when you’re sick. Penicillins are traditional, first-line therapies for many common infections, and often have the fewest side effects.
- Save money. Penicillin-class antibiotics are free or about $3 in many states. Substitute antibiotics are often Tier 3 drugs and can cost up to 12 times as much.
- Spend less time in the hospital with more appropriate antibiotic use.
About Dr Eric Macy
Fellow of the American Academy of Allergy, Asthma
and Immunology and the American College of Allergy
Asthma and Immunology
Eric Macy, MD has an active research interest in drug allergy, asthma diagnosis, and chronic urticaria (hives), and have been published extensively. He attended graduate school in microbiology and immunology at UCLA prior to medical school.
He is an assistant clinical professor of medicine in the Department of Medicine at UC San Diego and participates in medical student, medical resident, and allergy immunology fellowship trainings. He frequently lectures on drug allergy and asthma diagnosis at the American Academy of Allergy Asthma and Immunology (AAAAI).
He is currently the chair of the Southern California Kaiser Permanente Institutional Review Board, a committee that reviews all human-subject research performed in Kaiser Permanente’s Southern California region.
References:
- Caubet JC, Kaiser L, Lemaitre B, Fellay B, Gervaix A, Eigenmann PA. The role of penicillin in benign skin rashes in childhood; a prospective study based on drug rechallenge. J Allergy Clin Immunol 2011;127:218-22
- Goldberg A, Confino-Cohen R. Skin testing and oral challenge in patients with a history of remote penicillin allergy. Ann Allergy Asthma Immunol 2008;100:37-43
- Hetrshkovich J, Broides A, Kirjner L, Smith H, Gorodischer R. Beta lactam allergy and resensitization in children with suspected beta lactam allergy. Clin Exp Allergy 2009;39:726-30
- https://www.cdc.gov/
- http://www.choosingwisely.org/aaaai-releases-second-list-of-tests-and-procedures-that-are-overused-to-diagnose-and-treat-allergies-asthma-and-immunologic-diseases/
- http://www.nytimes.com/2015/03/03/opinion/are-you-really-allergic-to-antibiotics.html
- http://www.wsj.com/articles/SB10001424052702303779504579465563788334676
- Implementing an Antibiotic Stewardship Program: Guidelines by the IDSA and the SHEA http://cid.oxfordjournals.org/content/early/2016/04/11/cid.ciw118.full
- Johansson SGO, Adedoyin J, van Hage M, Gronneberg R, Nopp A. False-positive penicillin immunoassay: an unnoticed common problem. J Allergy Clin Immunol 2013;132:235-7
- Joint Task Force on Practice Parameters; American Academy of Allergy, Asthma, and Immunology; American College of Allergy, Asthma, and Immunology; Joint Council of Allergy, Asthma, and Immunology. Drug allergy: an updated practice parameter. Ann Allergy Asthma Immunol. 2010;105:259-273e1-78
- Lee P, Shanson D. Results of a UK survey of fatal anaphylaxis after oral amoxicillin. J Antimicrobial Chemotherapy 2007;60:1172-9
- Macy E, Contreras R. Healthcare utilization and serious infection prevalence associated with penicillin “allergy” in hospitalized patients: a cohort study. J Allergy Clin Immunol 2014;133:790-6.
- Macy E, Goldberg B, Poon KWT. Use of commercial anti-penicillin-IgE FEIAs to diagnose penicillin allergy. Ann Allergy Asthma Immunol, 2010;105:136-141
- Macy E, Mangat R, Burchette RJ. Penicillin skin testing in advance of need: multiyear follow-up in 568 test result-negative subjects exposed to oral penicillins. J Allergy Clin Immunol 2003;111:1111-5
- Macy E, Ngor EW. Safely diagnosing clinically significant penicillin allergy using only penicilloyl-poly-lysine, penicillin, and oral amoxicillin. JACI In Practice 2013;1:258-63
- Macy E, Schatz M, Lin C, Poon KWT. The falling rate of positive penicillin skin tests from 1995 to 2007. Perm J, 2009;13:12-18.
- Mill C, Primeau MH, Medoff E, et al. Assessing the diagnostic properties of a graded oral provocative challenge for the diagnosis of immediate and nonimmediate reactions to amoxicillin in children. JAMA Pediatr. doi:10.1001/jamapediatrics.2016.0033
- Murphy K, Scanlan B, Coghlan D. Does this child really have a penicillin allergy? Ir Med J 2015;108:103-6
- Solensky R, Earl HS, Gruchalla RS. Lack of penicillin resensitization in patients with a history of penicillin allergy after receiving repeated penicillin courses. Arch Inter Med 2002;162:822-6
- Solensky R. Penicillin allergy as a public health measure. J Allergy Clin Immunol 2014;133:797-8.